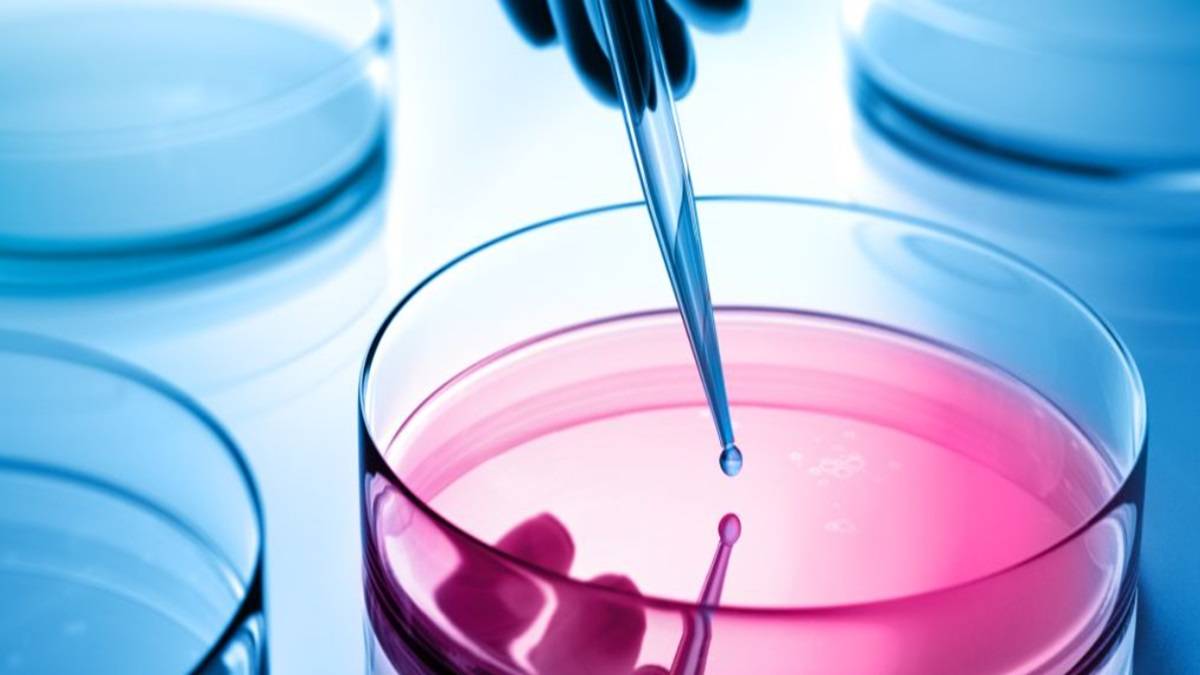

IOI Awards £5M To Oxford Researchers For Developing Therapies For Drug-resistant Tuberculosis
The Oxford researchers will work on a project which has five interconnected stages including Medicinal chemistry, in vitro and ex vivo evaluation, computational science and digital microbiology, in vivo evaluation, and clinical pipeline preparation.
Study in UK: The Ineos Oxford Institute for Antimicrobial Research (IOI) has offered £5 million to an Oxford group of 17 interdisciplinary researchers to develop novel therapies for drug-resistant tuberculosis.
Tuberculosis (TB) is caused by the bacterium Mycobacterium tuberculosis (Mtb). It is a deadly disease which affects the lungs and causes more than 1.2 million deaths every year. The traditional treatment for TB includes long courses of different types of antibiotics, but now the bacteria have developed antimicrobial resistance (AMR) which makes it difficult to treat TB, it takes more time for patients to recover and the treatment has also become costlier. Hence, there is an urgent need to develop treatment options for TB.

To address this global health threat, IOI has provided this funding for the setting up of an Oxford consortium comprising biologists, chemists, vaccinologists, clinicians and health sociologists who will work together through the 5 interconnected stages to develop new therapies.
Oxford Research On TB Treatments
Professor Sir Stewart Cole, Executive Chair of the IOI said, "Tuberculosis is a perfect example of how we are returning to the pre-antibiotic era. Over 95% of TB patients used to be cured but now multidrug-resistant TB has become a leading cause of death due to AMR. The IOI Grand Challenge award will bring together researchers with complementary skills to establish a successful pipeline for TB drug and therapeutic vaccine development spanning molecular epidemiology, medicinal chemistry, in vitro and in vivo evaluation, and clinical trials in regions most affected by this disease. TB and AMR cannot be solved in silos. The IOI Grand Challenge Award will facilitate collaborations across different disciplines and sectors to help solve this global health crisis."
Professor Rachel Tanner, Associate Professor, at Oxford University and Lead Principal Investigator (PI) for the project said, "The complex biology of the bacterium Mtb makes it inherently resistant to many potential drugs. There is a dearth of validated drug targets and investment towards new antibiotic discovery. The IOI Grand Challenge award will enable us to establish a cross-divisional collaborative and interdisciplinary research network with an integrated pipeline of therapeutic development to tackle the world’s most devastating pathogen."
Read more:
Pick your stage and get free guidance from counsellors who've helped thousands get into top universities.
 Starting research
Starting research Shortlisting colleges
Shortlisting colleges Exam preparation
Exam preparation SOP/LOR writing
SOP/LOR writing Scholarship & finance
Scholarship & finance Visa application
Visa application